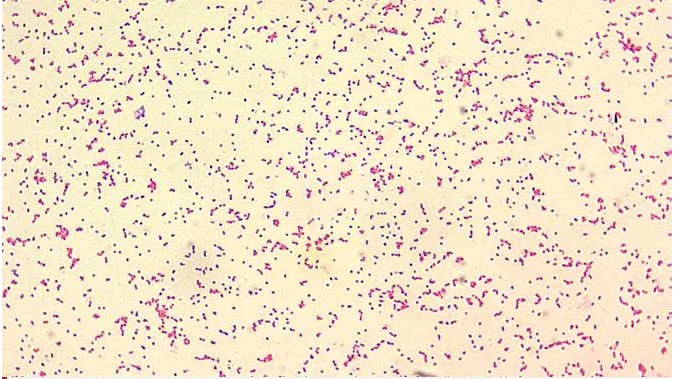

Ilustrasi bakteri penyebab penyakit Brucellosis (CDC/Courtesy of Larry Stauffer, Oregon State Public Health Laboratory)
JawaPos.com - Pandemi Covid-19 belum usai, namun Tiongkok dihadapkan wabah baru sejenis flu. Dikenal sebagai Brucellosis, penyakit dari bakteri dengan gejala mirip flu yang terjadi di barat laut Tiongkok.
Wabah ini disebabkan oleh kontak dengan hewan. Brucellosis adalah penyakit menular zoonosis, atau penyakit pada hewan yang dapat menyebar ke manusia. Penyakit ini disebabkan oleh bakteri yang menyerang domba, kambing, sapi, babi, dan bahkan anjing. Penyakit ini dilaporkan di banyak negara.
Baca juga: Cegah Gelombang Kedua Covid-19, Warga Inggris Dilarang Masuk Tiongkok
Manusia umumnya tertular penyakit ini melalui kontak langsung dengan hewan yang tertular melalui konsumsi produk hewani yang tercemar seperti susu atau keju. Atau melalui penghirupan yang terbawa udara.
Penularan penyakit ini dari manusia ke manusia sangat jarang menurut Organisasi Kesehatan Dunia (WHO). Gejala pada manusia termasuk demam dan kelelahan muncul selama beberapa minggu. Angka kematiannya rendah, meski komplikasi bisa menyebabkan kematian. Beberapa gejala seperti nyeri sendi bisa menjadi kronis dan tidak pernah hilang.
Wabah terbaru di Lanzhou pertama kali ditemukan pada November 2019 ketika beberapa siswa di Institut Penelitian Hewan Lanzhou dinyatakan positif brucellosis. Hingga akhir Desember, setidaknya 181 orang di institut tersebut telah terinfeksi menurut otoritas kesehatan provinsi.
Photo
Ilustrasi bakteri penyebab penyakit Brucellosis (CDC/Courtesy of Larry Stauffer, Oregon State Public Health Laboratory)
Wabah bahkan menyebar ke Provinsi Heilongjiang di sudut timur laut Tiongkok. Diketahui 13 orang yang bekerja di institut dokter hewan pada Agustus 2019 dinyatakan positif.
"Pemerintah telah menguji 55.725 orang di kota itu, 6.620 di antaranya positif brucellosis hingga saat ini," kata pemerintah Lanzhou pada konferensi pers menurut laporan Global Times.
Wabah berasal dari pabrik biofarmasi milik Industri Peternakan Tiongkok yang terdaftar di Shanghai. Pabrik telah menggunakan disinfektan yang kedaluwarsa pada Juli hingga Agustus 2019 untuk membuat vaksin brucellosis. Sehingga, meninggalkan bakteri dalam gas limbahnya. Gas yang terkontaminasi kemudian membentuk aerosol yang mengalir terbawa arah angin ke institut kedokteran hewan.
Sekitar setengah juta orang yang terinfeksi dilaporkan setiap tahun di seluruh dunia. Tiongkok sendiri biasanya mencatat puluhan ribu kasus.
Pada 2019, Tiongkok melaporkan 44.036 kasus dengan satu kematian, naik dari 37.947 kasus dan nol kematian setahun sebelumnya. Kasus pertama yang dilaporkan di Tiongkok terjadi di Kota Chongqing pada 1905. Tiongkok mengalami epidemi brucellosis yang meluas pada 1950-an dan 1960-an. Tahun lalu, Tiongkok melaporkan lebih dari 10 juta kasus penyakit menular termasuk brucellosis, disentri, dan demam berdarah.

Dana Desa Dialihkan untuk Koperasi Merah Putih, Pembangunan Desa di Bantul Jalan dengan Skema Lain
Wisata Kuliner Kabupaten Malang: 7 Makanan Khas yang Legendaris, Unik dan Autentik untuk Food Lovers
Link Pengumuman Hasil Seleksi Administrasi Manajer Koperasi Merah Putih yang Sudah Diumumkan
14 Rekomendasi Kuliner Depok untuk Keluarga, Tempat Makan Nyaman dengan Menu Beragam
50 Unit Mobil Koperasi Desa Merah Putih Tiba di Wonogiri, Dandim 0728/Wonogiri: Saran Saya Tidak Usah Digunakan Dulu Mobilnya
7 Rekomendasi Kuliner Lontong Balap Paling Enak di Surabaya, Wajib Dicoba Sekali Seumur Hidup!
Sempat Di-blacklist Koramil, Pembangunan Koperasi Merah Putih di Tuban Dikawal Babinsa
17 kuliner Legendaris di Surabaya yang Wajib Dicicipi Sekali Seumur Hidup!
12 Restoran Sunda Paling Enak di Jakarta, Tempat Makan dengan Menu Tradisional Khas dari Tanah Pasundan
Kecelakaan Kereta dan KRL di Bekasi Timur, KAI Fokus Evakuasi Para Korban
